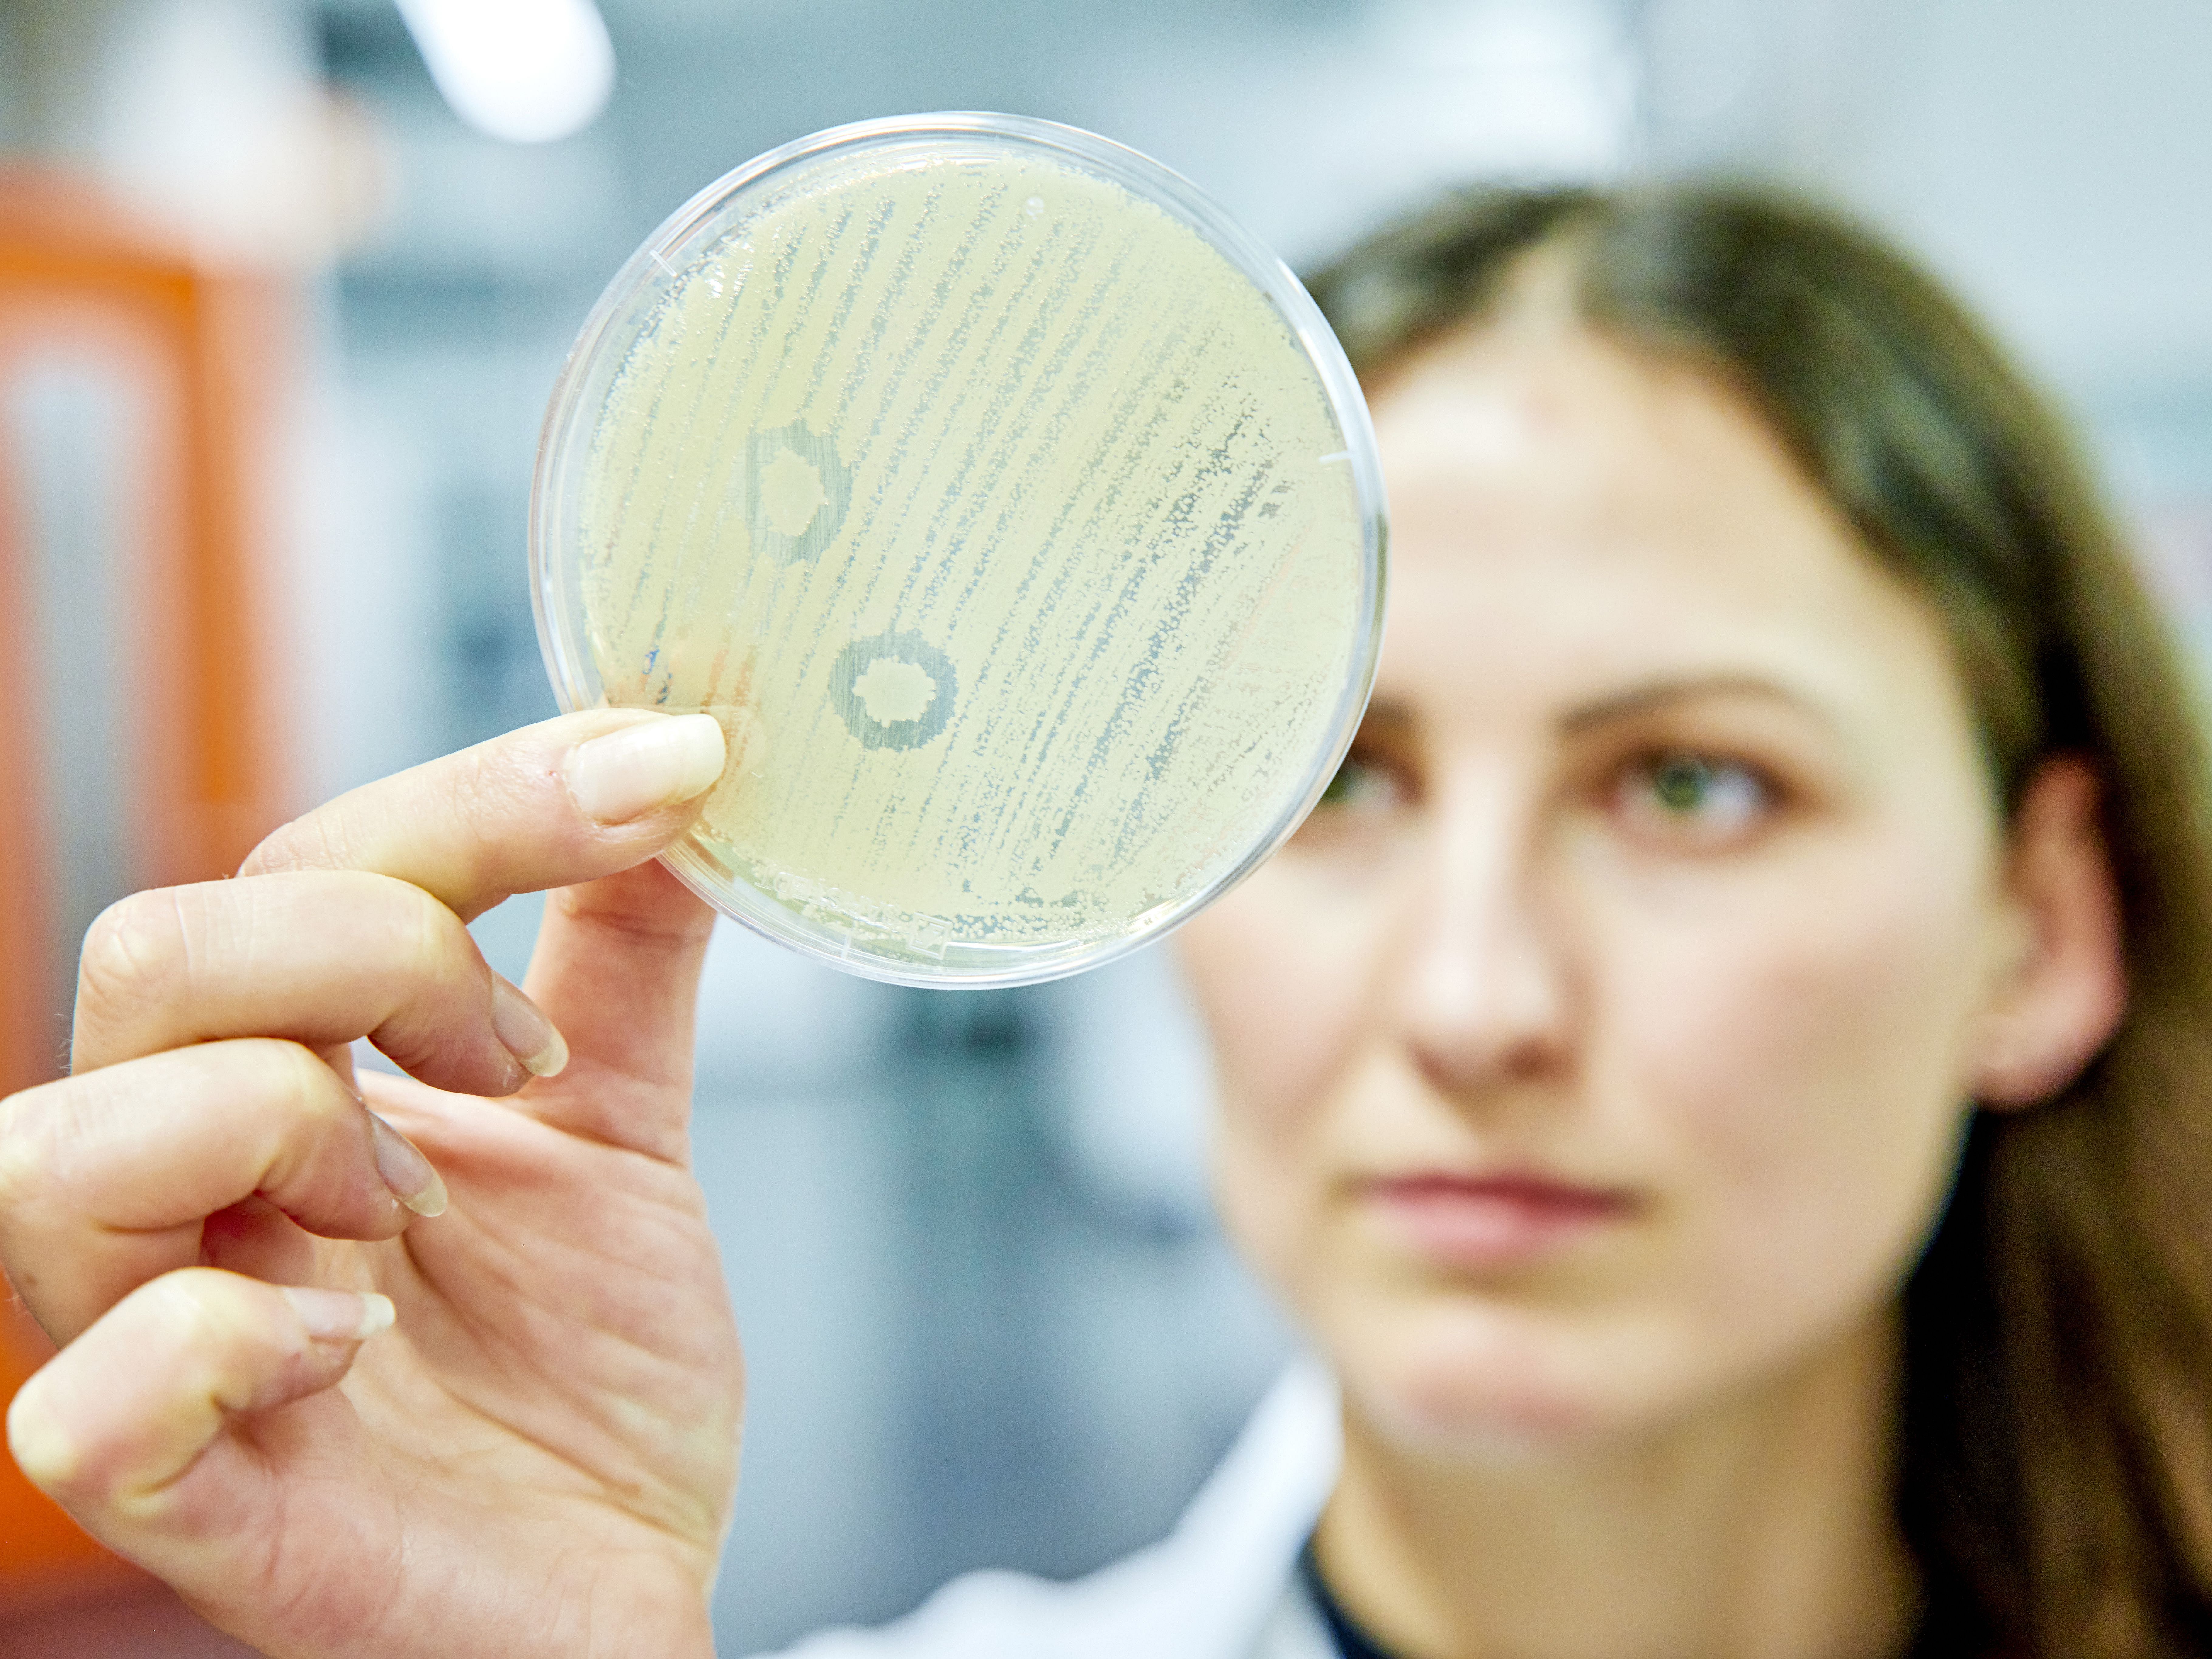

Master of Microbiology and Infection Biology
Scientific profile
Tübingen as a place to study
Research networks
External content
Actually, you are supposed to see a video here. To display this content (source: www.xyz.de), please click the "Accept" button below. Please note that by viewing the video, data might be transmitted to third parties or cookies may be stored.
For further information see our privacy policy.
No news available.